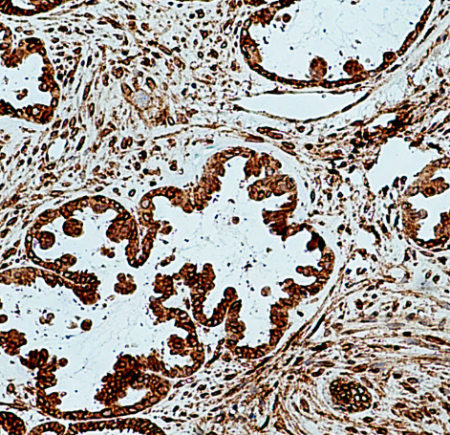

CXCL10/IP-10 Rabbit Polyclonal Antibody
CAT.NO. : ARA6510
RMB Please choose
RMB Please choose
*产品价格可能会有所调整,请以品牌方官网实时更新的价格为准,以确保准确性。
Background
CXCL10 (also known as IP-10) is a member of the CXC chemokine family which binds to the CXCR3 receptor to exert its biological effects. CXCL10 is a 12-kDa protein and constitutes two internal disulfide cross bridges. The predicted signal peptidase cleavage generates a 10-kDa secreted polypeptide with four conserved cysteine residues in the N-terminal. The CXCL10 gene localizes on chromosome 4 at band q21, a locus associated with an acute monocytic/B-lymphocyte lineage leukemia exhibiting translocation of t (4; 11) (q21; q23). CXCL10 mediates leukocyte trafficking, adaptive immunity, inflammation, haematopoiesis and angiogenesis. Under proinflammatory conditions CXCL10 is secreted from a variety of cells, such as leukocytes, activated neutrophils, eosinophils, monocytes, epithelial cells, endothelial cells, stromal cells (fibroblasts) and keratinocytes in response to IFN-γ.
Application
|
Application |
Dilution Ratio |
|
WB |
1:500 - 1:2000 |
|
IHC |
1:200 - 1:800 |
|
1:100 - 1:200 |
Overview
|
Validated Applications |
WB, IHC, IF |
|
Species Reactivity |
Human, Mouse, Rat |
|
Immunogen |
Recombinant human CXCL10 protein |
|
Host/Isotype |
Rabbit / IgG |
|
Antibody Class |
Polyclonal |
|
Product Type |
Antibody |
|
Full Name |
chemokine (C-X-C motif) ligand 10 |
|
Alternative Names |
CXCL10, CXCL10/IP10, IP10, 10 kDa interferon gamma-induced protein, C X C motif chemokine 10 |
|
Calculated Molecular Weight |
11 kDa |
|
Observed Molecular Weight |
11 kDa |
|
GenBank Protein Accession |
BC010954 |
|
Gene Name |
CXCL10 |
|
Gene ID (NCBI) |
3627 |
|
Conjugation Type |
Unconjugated |
|
Form |
Liquid |
|
Purification Method |
Antigen affinity purification |
|
UNIPROT ID |
P02778 |
|
Storage Buffer |
PBS with 0.02% sodium azide and 50% glycerol, pH 7.3. |
Data

Untreated, IFN gamma, LPS and Brefeldin A treated THP-1 cells were subjected to SDS PAGE followed by western blot with CXCL10/IP-10 Rabbit Polyclonal Antibody.
Immunohistochemical analysis of paraffin-embedded human ovary tumor tissue slide using CXCL10/IP-10 Rabbit Polyclonal Antibody.

Immunofluorescent staining of spinal cord tissues from mice 8 weeks post-SCI with CXCL10/IP-10 Rabbit Polyclonal Antibody.
Storage
Store at 4°C short term. For long term storage, store at -20°C, avoiding freeze/thaw cycles.
Research Use Only
For Research Use Only. Not for use in diagnostic procedures.
New Products
